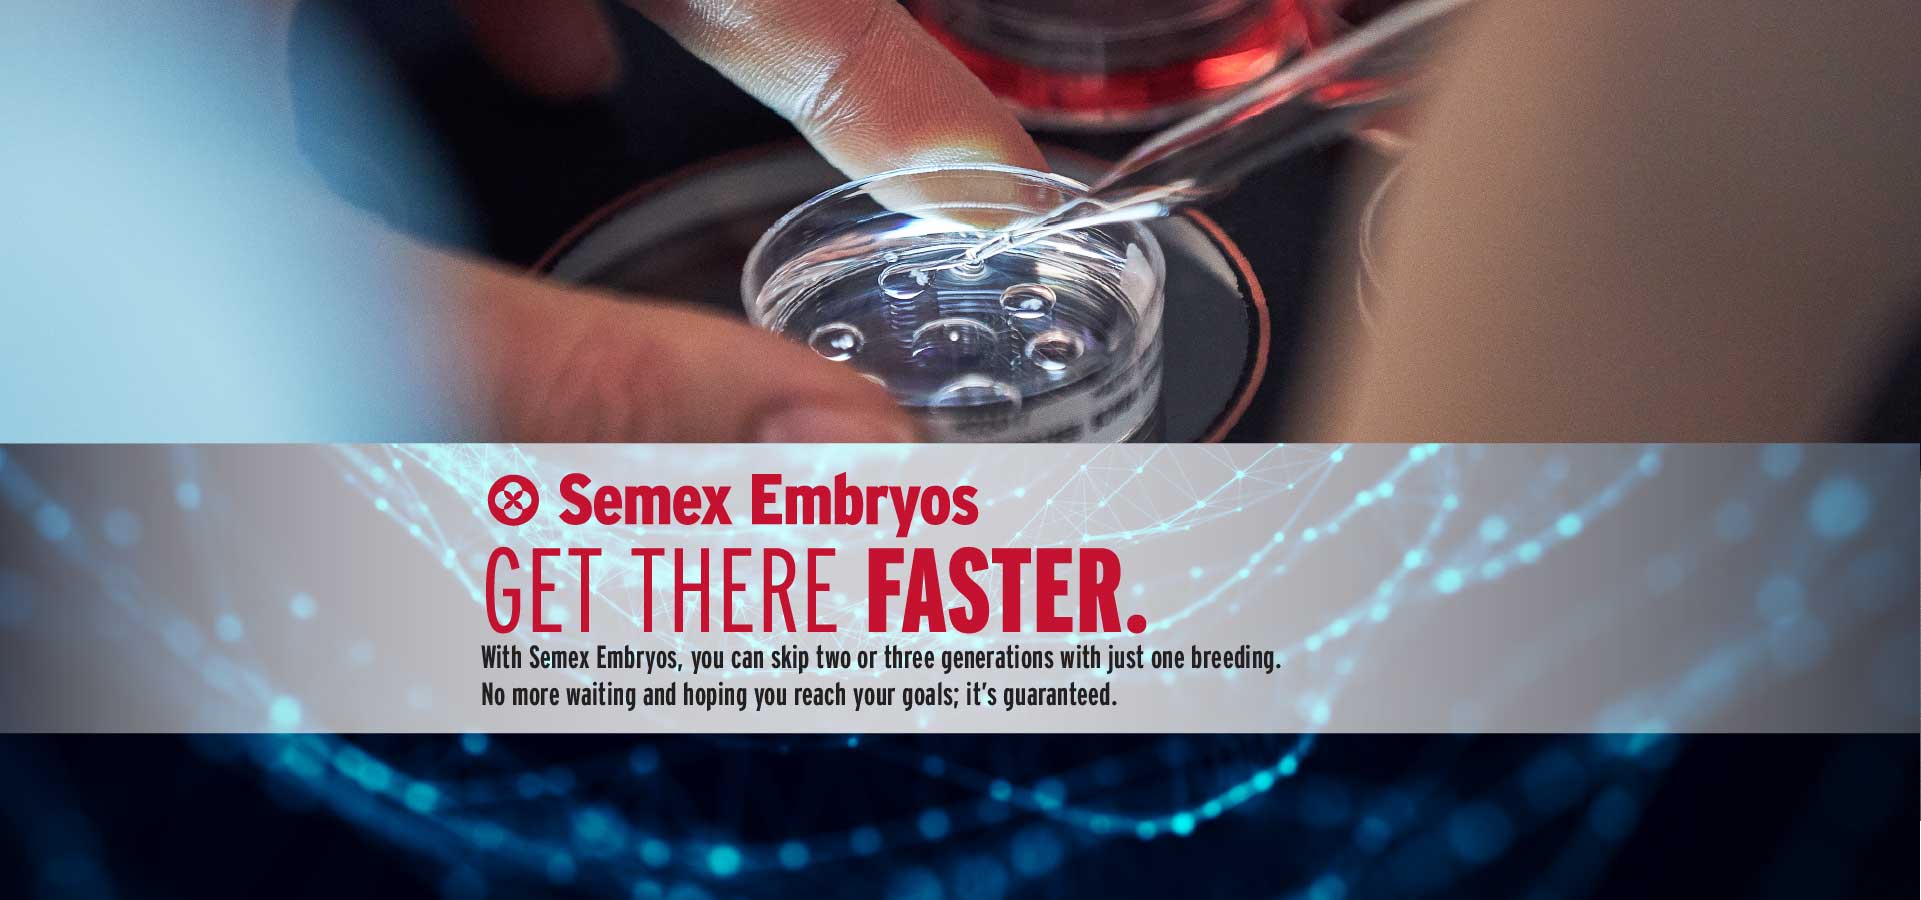
Embryosweb_bannersENG-01.jpg

Targeting fertility, health and longevity to build a profitable herd
The only company offering immune genetics for greater disease resistance.
Delivering the world's most in-demand and profitable sires.
Fewer difficult births make your herd a profitable herd.
Advance your herd at the fastest pace
Control your herd's genetic future with more heifers.
Superior genetics for Robot Ready™ sires are an asset for automated dairies.
Sires designed to make management in grazing environments as effortless as possible.
High fertility sires with no genetic sacrifices for quality.
Adding Profitability to Dairies with Beef Up sires
Meeting the demand for homozygous A2 sires.



